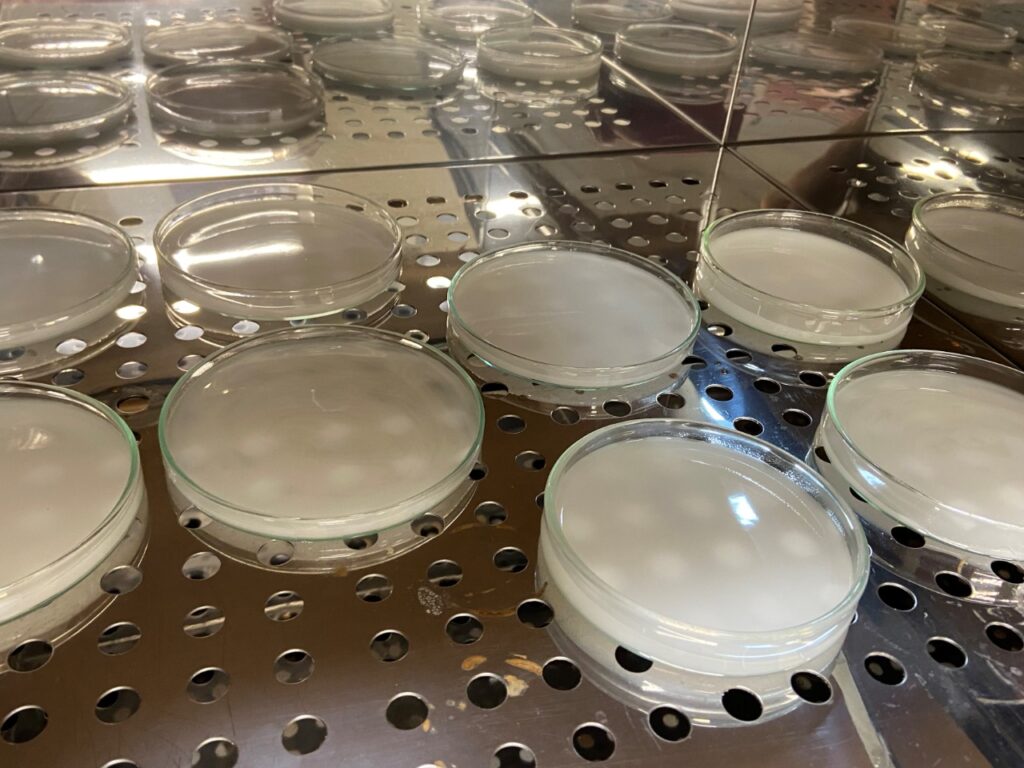
Biofilme de erva-mate, FURB

Uma pesquisa desenvolvida na Universidade Regional de Blumenau (FURB) pode revolucionar o mercado de embalagens sustentáveis. Um trabalho de mestrado desenvolveu uma embalagem biodegradável, com ingredientes exclusivamente de origem vegetal, que muda de cor quando o alimento deteriora. Uma de suas principais matérias-primas? A erva-mate.
A embalagem foi desenvolvida em uma pesquisa de pós-graduação pela acadêmica Eduarda Mueller, orientada pela professora Carolina Krebs de Souza, e visa atender a dois objetivos: impactar a redução de plástico comumente utilizado em embalagens e criar produtos inteligentes para reduzir o desperdício de alimentos. O biofilme criado à base de erva-mate atende a essas duas necessidades.

O teste principal foi feito com pescado e demonstrou o resultado esperado: a embalagem muda a cor quando o peixe começa a estragar, informando ao consumidor de maneira visual que o alimento não é mais apto para consumo. Ao invés de se basear na data de validade expressa no rótulo de um alimento, por exemplo, o consumidor poderá apenas analisar a cor da embalagem para ter a segurança de um produto ainda preservado.
A sustentabilidade é um destaque: a embalagem é formulada somente com produtos de origem vegetal – sendo comestível, ela engloba o mercado vegano. Além disso, quando descartada no solo, é degradada em apenas 2 semanas.
“O mundo inteiro está trabalhando e investindo na pesquisa e no desenvolvimento de possibilidades que reduzam o impacto ambiental, como as embalagens biodegradáveis, e não só por uma questão ética, mas pela necessidade de atender esta exigência do consumidor. Não faz sentido consumirmos em alguns minutos um produto que tenha uma embalagem que impacte negativamente, por dezenas de anos, o meio ambiente. O perfil do consumidor de 2030 vai optar por consumir produtos de indústrias que enfatizem esta preocupação”, defende Carolina.
Nesse biofilme, a erva-mate tem papel fundamental. “Um dos maiores problemas na deterioração de alimentos é a oxidação, por isso pensamos na erva-mate, que tem poder antioxidante cientificamente comprovado”, conta a mestranda Eduarda. A erva-mate, porém, não é apenas antioxidante, mas também antimicrobiana, o que reduz a incidência de bolores e leveduras nos alimentos, prolongando sua vida útil.
O teste principal feito com pescado indicou resultados promissores no controle microbiano, aumentando a conservação do alimento. O material desenvolvido passou pelos testes que demonstram a eficiência em manter vácuo e resistência a selagem.
A pesquisa está sendo desenvolvida há dois anos e está na etapa de avaliação para o depósito de patente, devido a seu potencial inovador. Em alguns anos, uma embalagem a base de erva-mate pode estar nas prateleiras dos supermercados.
Valorização
A ideia de desenvolver uma embalagem que contivesse como ingrediente a erva-mate surgiu em conversas com a pesquisadora Cristiane Helm, da Embrapa Florestas, coorientadora do projeto de mestrado que resultou no biofilme. Um dos objetivos é valorizar os produtos da região sul do Brasil.
Parcerias com multinacionais que desenvolvem sistemas de refrigeração impulsionaram as pesquisas sobre preservação de alimentos associado à refrigeração e novos materiais. O grupo de pesquisa de Engenharia Bioquímica e Alimentos (GENBIA) da FURB desenvolve inúmeros outros projetos sobre materiais biodegradáveis para aplicação em alimentos, tendo base outros ingredientes como extrato de jabuticaba, própolis e aloe vera.